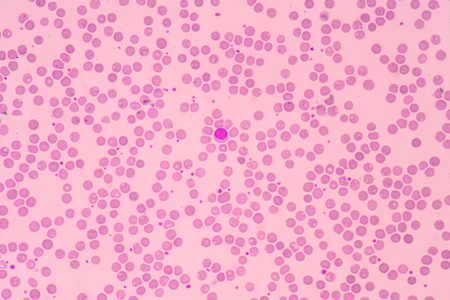
blood smear is often used as a follow-up test to abnormal results on a complete blood count (CBC) to evaluate the different types of blood cells.の写真素材

写真素材 - blood smear is often used as a follow-up test to abnormal results on a complete blood count (CBC) to evaluate the different types of blood cells.
作品情報
blood smear is often used as a follow-up test to abnormal results on a complete blood count (CBC) to evaluate the different types of blood cells.
- ID:56877345
- 作品種別:写真
- 作者名:toeytoey
キーワード
- allergy
- antibody
- antigen
- asthma
- b
- basophil
- blood
- care
- cell
- diagram
- differentiation
- disease
- elements
- eosinophil
- health
- healthcare
- healthy
- human
- immune
- immunity
- immunology
- infection
- inflammation
- killer
- leukocyte
- lymph
- lymphocyte
- lymphoid
- macrophage
- medical
- medicine
- microbiology
- monocyte
- mononuclear
- neutrophil
- nucleus
- overview
- pathogens
- phagocyte
- progenitor
- receptor
- response
- science
- structure
- system
- white
類似作品
Anatomy and His...
Blood test in a...
watercolor pain...
Syringe of Red ...
a drop of red b...
Social crime ob...
Syringe of Red ...
Drops of blood ...
Syringe of Red ...
Syringe of Red ...
Syringe of Red ...
drops of red bl...
Eggs of a Taeni...
Hands, blood an...
Abstract backgr...
Syringe of Red ...
Syringe of Red ...
Close up shot o...
Close-up of a b...
Abstract art fe...
Wine splatter o...
watercolor drop...
red drops of hu...
Red imprint of ...
Splattered bloo...
Syringe of Red ...
Eggs of tapewor...
Syringe of Red ...
Lipstick smeare...
Abstract liquid...
Syringe of Red ...
Syringe and via...
Syringe of Red ...
syringe and red...
Wine stains on ...
Laboratory anal...
Syringe of Red ...
Photo of the Sy...
isolated red dr...
Stain of blood ...
Red Blood splas...
Little brush pa...
pink ink drops ...
Mycobacterium a...
blood syringe f...
Blood splatter ...
Red imprint of ...
White shirt wit...
Closeup Macro i...